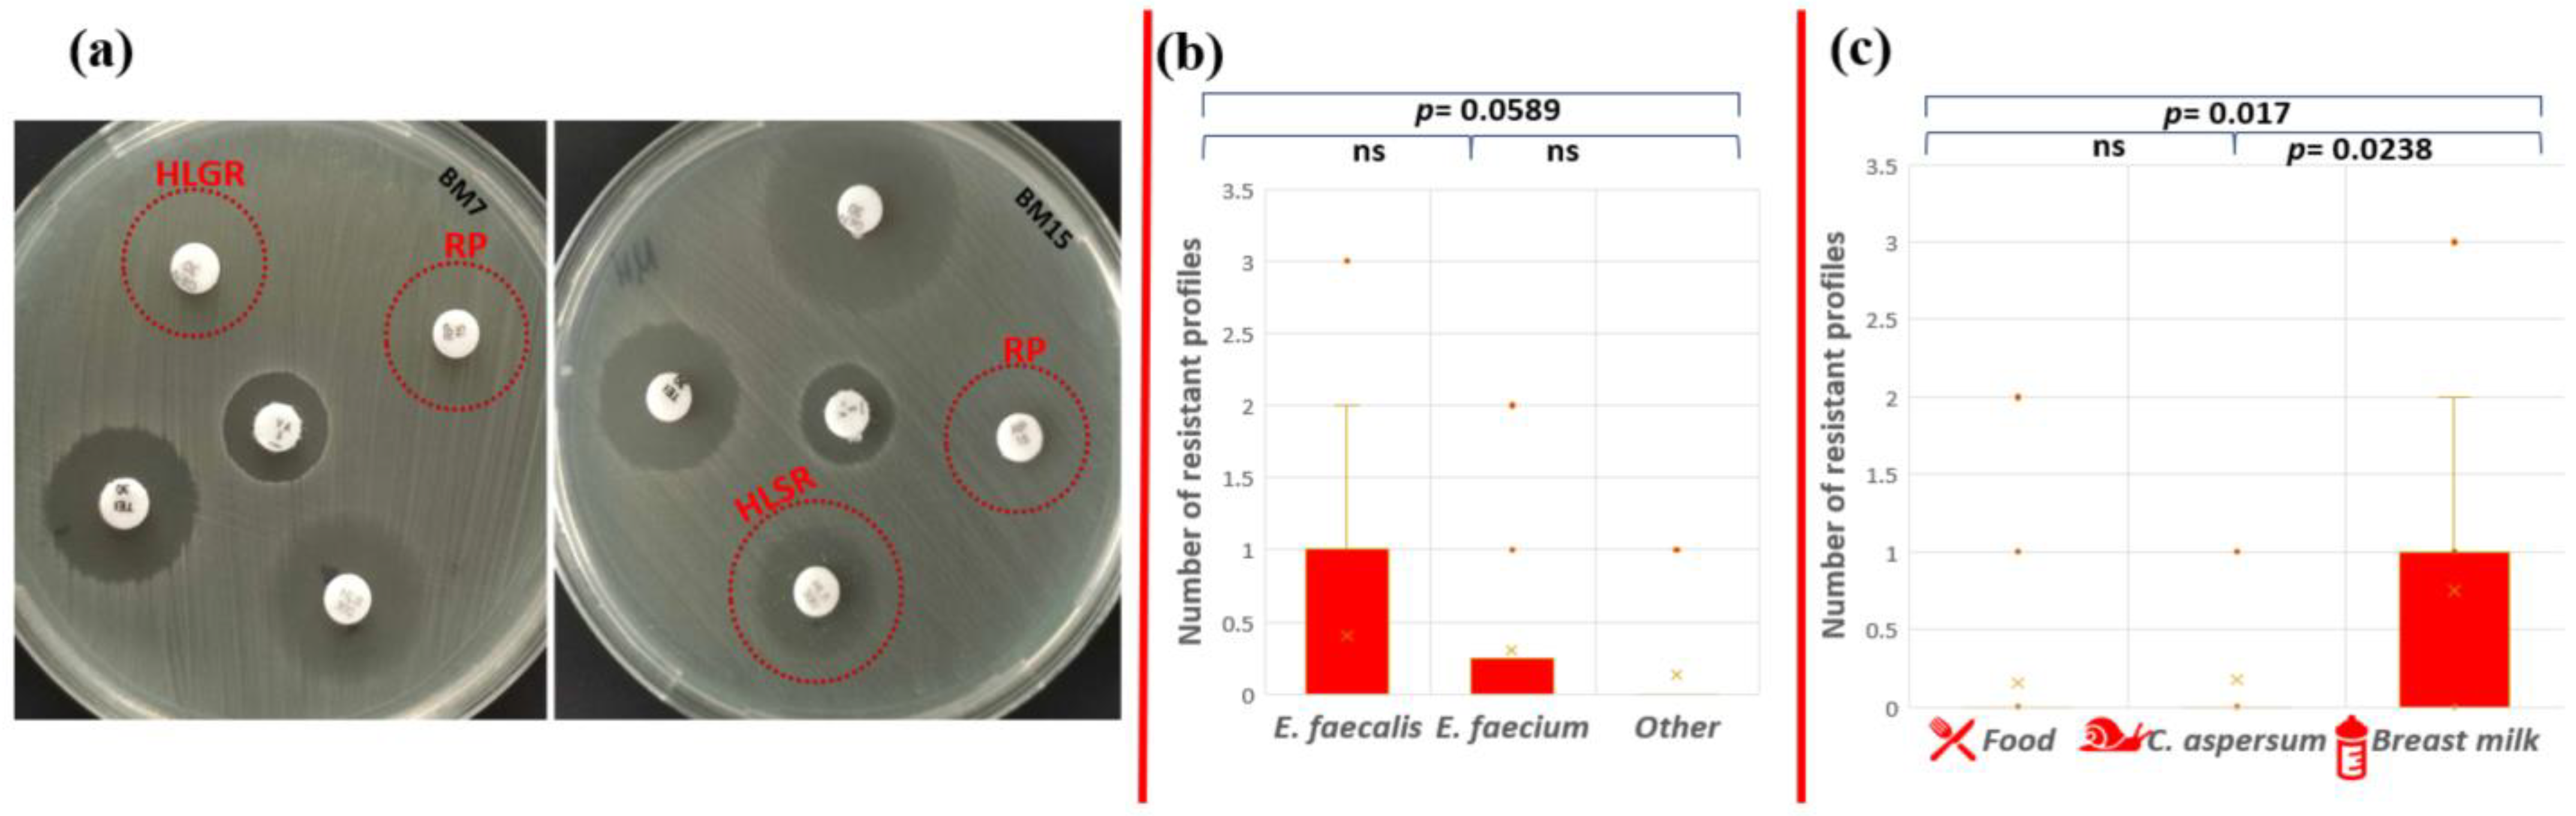
Pathogens 13 00036 g005

Abstract
The pathway and the lifestyle of known enterococcus species are too complicated. The aim of the present study is to trace the path of pathogenicity of enterococci isolated from seven habitats (Cornu aspersum intestine; Bulgarian yoghurt; goat and cow feta cheese—mature and young, respectively; Arabian street food—doner kebab; cow milk; and human breast milk) by comparing their pathogenic potential. In total, 72 enterococcal strains were isolated and identified by MALDI-TOF, sequencing, and PCR. Hemolytic and gelatinase activity were biochemically determined. PCR was carried out for detection of virulence factors (cylB, esp, gls24, nucl, psaA, agg, gelE, and ace) and antibiotic resistance (erm, ermB, blaZ, vanA, aphA, mefA, gyrA, catpIP501, and aac6′-aph2″). Phenotypic antibiotic resistance was assigned according to EUCAST. Eleven representatives of the genus Enterococcus were identified: E. mundtii, E. casseliflavus, E. gilvus, E. pseudoavium, E. pallens, E. malodoratus, E. devriesei, E. gallinarum, E. durans, E. faecium, and E. faecalis. Twenty-two strains expressed α-hemolysis. Thirteen strains had the cylB gene. Only two strains expressed α-hemolysis and possessed the cylB gene simultaneously. Positive amplification for gelE was found in 35% of the isolates, but phenotypic gelatinase activity was observed only in three strains. All isolates showed varying antibiotic resistance. Only E. faecalis BM15 showed multiple resistance (AMP-HLSR-RP). Correlation between genotypic and phenotypic macrolide resistance was revealed for two E. faecalis strains.
1. Introduction
The members of the genus Enterococcus are bacteria that have a dual role in the environment: positive (as commensal and potential probiotic bacteria) and negative (opportunistic pathogens capable of infecting plants, animals, and humans) [1]. The pathway and the lifestyle of known enterococcus species in the natural environment are far too complicated and poorly studied. Most studies characterize enterococci isolated from particular ecological niches and do not track what features they develop when they jump from one biological kingdom to another.
Enterococci are ubiquitous Gram-positive bacteria that can be found in various ecological niches, such as environmental, clinical, and food. This genus of bacteria forms a part of natural biomes of soil, water, sewage, and arable land, as well as populations in the gastrointestinal tracts (GITs) of mammals, birds, fishes, invertebrates, and insects [2,3,4,5,6]. Similarly, enterococci have been isolated from fresh vegetables (olive, pepper, celery, cilantro, mustard greens, spinach, collards, parsley, dill, cabbage, and cantaloupe) and wild plants also [7,8,9,10]. Flowering plants and crops have also been known to be carriers of enterococci [11]. Mundt [10] states that relationships between enterococci and plants are based mainly on their epiphytic persistence. However, they have been considered temporary inhabitants as a result of wind and insect activity [10].
Enterococci are a diverse taxonomic group that includes 58 recognized species and 2 subspecies [12]. The most distributed members of the genus in the GITs of mammals have been reported to be Enterococcus faecalis, Enterococcus faecium, Enterococcus durans, and Enterococcus hirae [13]. Plant-associated epiphytic Enterococcus species most commonly belong to E. faecalis, Enterococcus mundtii, Enterococcus casseliflavus, E. faecium, and Enterococcus sulfureus [11,14,15]. A new taxonomic species, Enterococcus plantarum sp. nov., was identified during the study of the microflora of various plants from meadows [16]. However, most studies assume that enterococci, as part of the natural microbiota of the gastrointestinal tract of warm-blooded animals, can enter the environment through feces, contaminate soil and water, and then colonize plants. This pathway explains why enterococci predominate on plant surfaces and are resistant to a number of antibiotics [17,18,19,20], but at the same time, they can be identified as potential cross-over agents promoting the dissemination of antibiotic resistance [8,21]. Furthermore, it has been suggested that the infection strategies of some enterococci (E. faecalis) are similar in plants, mammals, and nematodes [1].
Moreover, evidence that some strains of E. faecalis can infect the roots and leaves of the plant Arabidopsis thaliana, causing local and systemic infection that leads to the death of the infected plant, has been reported [1]. E. faecalis has developed a significant biofilm-like pathogenic community that has colonized the root surface [1]. Enterococci have been previously reported as a component of the microbiome of pepper plants with symptoms of disease [8].
On the other hand, it can be assumed that enterococci are part of the plant microbiome and that they enter the intestinal tracts of animals and humans through the intake of plant food. Each gut microbiome selects the enterococcal species it needs to maintain eubiosis. Colonizing different microbiomes, from invertebrates to mammals, allows plant enterococci to acquire new genes, which they then spread into new environmental niches. This life cycle of passing through hosts from different biological kingdoms defines enterococci as important vectors for the horizontal transfer of antibiotic resistance and virulence genes, despite where they originate from [22].
Traditionally, enterococci have been considered to be normal commensal bacteria and may even be beneficial for a variety of gastrointestinal and systemic illnesses. Some enterococci species have the ability to stimulate the immune system and play an important role in the maintenance of intestinal homeostasis [23,24]. Similarly, enterococci have an active part in food technology as the starting culture in meat and cheese fermentation [25], as well as in food preservation [26,27,28].
However, enterococci can cause invasive infections if their relationship with the host is broken [29]. These bacteria exhibit remarkable adaptability in colonizing different hosts and show the ability to thrive as pathogens in diverse ecological niches [30]. However, some strains have acquired a wide range of virulence and antibiotic resistance genes, leading to an increase in their pathogenicity and posing a significant public health challenge [31,32]. Thus, enterococci, despite their commensal nature, have been identified as the most prevalent causes of urinary tract infections and nosocomial bacteremia. They also constitute the second most commonly reported cause of surgical wound infections and the third most often reported cause of bacteremia [33,34]. Moreover, enterococci have been reported as the main Gram-positive bacteria causing hospital-acquired infections during and after the COVID 19 pandemic [35,36,37,38,39,40].
The virulence factors that contribute to enterococcal pathogenesis include collagen-binding protein (Ace), aggregation substance (Agg), surface proteins (Esp), cytolysin (Cyl), gelatinase (Gel), general stress protein (Gls24), and immune evasion molecules [41]. Defined as effector molecules, virulence factors indicate a high potential of enterococci for host adherence, tissue invasion, immune evacuation, and nutrient acquisition. Ace is an adhesin, anchored to the cell wall, that helps enterococcal species to adhere to collagen. The agglutination substance (Agg) is a pheromone-inducible surface protein which helps in aggregation during the conjugation process. Cytolysin (Cyl) production is associated with the capacity of bacteria to access the bloodstream and trigger septicemia. Epidemiological research has found that the enterococcal surface protein, Esp, is typically linked with infectious strains, compared to commensal isolates, and is located on a large pathogenicity island [42]. Esp is also involved in initial adherence and biofilm formation and contributes to the pathogenesis of different infections. Gelatinase (Gel) is a zinc metallo-endopeptidase which takes part in pathogenesis by making nutrients available through degradation of host tissue and by taking part in biofilm formation [43].
A notable feature of enterococci is their intrinsic resistance to cephalosporin, cotrimoxazole, lincomycin, and low levels of penicillin and aminoglycosides. Enterococci can also acquire resistance genes from other microorganisms through horizontal gene transfer and thus become resistant to a variety of antibiotics such as chloramphenicol, tetracycline, streptogramin, macrolides, a high level of glycopeptide, aminoglycosides, and quinolones [44]. This acquired resistance along with their known remarkable ability to overcome and adapt to various environmental stress factors, give the enterococci the unique potential to realize complex lifestyles [45].
Therefore, the study of the diversity and distribution of pathogenicity-determining genes of enterococcal populations of different origins provides valuable insight into their adaptive strategies in different hosts and environments. It is also critical to understand the pathogenicity mechanisms that these multi-host pathogens possess. Moreover, the comparison of the virulence and resistance arsenal of the enterococcal populations, adapted to inhabit completely different niches, contributes to the global knowledge of enterococcal lifestyle and reveals the key role of the evolutionary pressure of the habitat on it. The present study considers enterococcal populations from different biological kingdoms/origins as a reservoir of genes for virulence and antibiotic resistance with respect to possible re-return into the environment and subsequent colonization of plants or other diverse ecological niches such as soil and water. The aim is to compare the pathogenic potential of enterococci isolated from herbivorous invertebrate animals, food products derived from herbivorous warm-blooded animals, and human breast milk.
2. Materials and Methods
2.1. Sample Collection and Isolation of the Bacteria
In total, twenty-seven samples from animal GIT (invertebrate herbivorous species Cornu aspersum at the hibernation stage of the life cycle) and food (Bulgarian yoghurt; goat and cow feta cheese—mature and young, respectively; Arabian street food—doner kebab; cow milk; and human breast milk) were used for Enterococcus species isolation. Breast milk samples were supplied by the Human Milk Bank, Bulgaria, C. aspersum samples were collected and processed according to Koleva et al. [46], and food samples were obtained randomly from artisanal markets. Approximately 1 g or 1 mL from each sample was homogenized in saline (at a ratio of 1:9) and all samples were directly cultivated on the selective medium Slanetz and Bartley agar (HiMedia Laboratories, Mumbai, India). The plates were cultivated at 37 °C for 24 h–48 h. The appearance of dark red-brownish colonies on the surface of the used media after the cultivation served as positive results for selection of enterococcal strains. Pure cultures from separate colonies were isolated as potential Enterococcus species after double purification. Three reference strains were also used in this study: E. faecalis NBIMCC 3915 and E. faecium NBIMCC 8754 as positive controls for the genus and species PCR identification, and Bacillus cereus NBIMCC 1085 as positive control for β-hemolytic activity in the hemolysis assay.
2.2. DNA Preparation
The bacterial cultures were cultivated in MRS broth (HiMedia, Mumbai, India) at 37 °C for 24 h prior to the genomic DNA extraction. The biomass was harvested by centrifugation at 10,000× g and was washed twice with 500 µL 1% NaCl. Total DNA was extracted by E.Z.N.A. Bacterial DNA Kit (Omega Biotek Inc., 400 Pinnacte Way, Suite 450, Norcross, GA, USA). For improved lysis of the cells, 2 µL 1000 units/mg mutanolysin (Merck KGaA, Darmstadt, Germany) was added at the enzyme lysis step.
2.3. Species Identification
The isolates were identified by three different methods: PCR with genus- and species-specific primers [46,47], 16S rRNA sequencing [46], and MALDI-TOF (Matrix-Assisted Laser Desorption/Ionization Time-of-Flight) mass spectrometry [8]. Genus- and species-specific PCRs were performed in a total reaction volume of 25 µL containing 16.5 µL ultrapure H2O, 0.5 µL (5 pmol/µL) of each primer, 6.5 µL VWR Red Taq polymerase master Mix (VWR International bvba/sprl, Haasrode Researchpark Zone 3, Geldenaaksebaan 464 B-3001, Haasrode Belgium), and 1 µL extracted DNA. The reactions conditions were as follows: initial denaturation at 95 °C for 5 min, followed by 25 cycles of denaturation at 94 °C for 45 s, annealing at 58 °C, 50 °C, 60 °C, and 55 °C, according to primer specificity [46,47] for 45 s, extension step at 72 °C for 45 s, and a final extension step at 72 °C for 7 min. PCR products were separated in 1.5% agarose gel electrophoresis at 100 V for 30 min, stained with ethidium bromide, and visualized under UV light. Molecular size marker 100 bp DNA ladder (SERVA FastLoad 100 bp DNA ladder, SERVA Electrophoresis GmbH, Carl-Benz-Str. 7, Heidelberg, Germany) was used. The universal primers 9F and 1542R were used to amplify the 16S rRNA gene [48]. Purified PCR products were sequenced in Macrogen Europe, Meibergdreef 57 1105 BA, Amsterdam, The Netherlands. The obtained sequences were subjected to comparative analyses using nucleotide BLAST (NCBI, accessed on June 2021).
2.4. Phenotypic Hemolytic Activity Assay
The evaluation of hemolytic activity was performed according to the method described by Carrillo et al. [49]. Pure bacterial cultures were cultivated overnight on brain heart infusion (BHI) agar (HiMedia Inc., Mumbai, India) to obtain log-phase cultures. Then, the cultures were surface spot inoculated on Columbia agar plates supplemented with 5% horse blood and incubated at a temperature of 37 °C for a duration of 24 to 48 h, after which the plates were examined for hemolysis. Clear zones around the colonies were interpreted as β-hemolysis (positive) and lack of zone was reported as gamma-hemolysis (negative). When greenish zones were observed, the strains were reported as α-hemolytic and taken as negative for the assessment of β-hemolytic activity [50].
2.5. Phenotypic Gelatinase Activity Assay
The evaluation of phenotypic gelatinase activity was carried out according to the procedure described by [41]. Pure bacterial cultures were cultivated overnight on BHI agar (HiMedia Inc., India) to obtain log-phase cultures. Then, the cultures were surface spot inoculated on agar plates containing 5 g/L peptone (Merck, Darmstadt, Germany), 30 g/L gelatin (Difco, Detroit, MI, USA), 3 g/L yeast extract (Gibco, Paisley, Scotland), and 15 g/L agar (Plant agar, Duchefa Biochemie, The Netherlands), with a pH of 7.0, and were incubated at 37 °C for 48 h. After the cultivation, the agar surface was flooded with a saturated solution of (NH3)2SO4 (55 g/100 mL dH2O). Gelatinase producers formed clear zones around the spots, and these results were interpreted as positive.
2.6. Antibiotic Susceptibility Testing
Susceptibility to antibiotic substances was performed using the Kirby–Bauer disc diffusion method [51]. For evaluation of antibiotic resistance of enterococcal isolates, fifteen antibiotics were tested: ampicillin 2 μg/disc (AMP), imipenem 10 µg/disc (IPM), ciprofloxacin 5 µg/disc (CP), levofloxacin 5 µg/disc (LE), norfloxacin 10 µg/disc (NX), gentamicin 30 µg/disc—test for high-level aminoglycoside resistance (GEN), streptomycin 300 µg/disc—test for high-level streptomycin resistance (HLS), teicoplanin 30 µg/disc (TEI), vancomycin 5 µg/disc (VA), quinupristin-dalfopristin 15 µg/disc (RP), eravacycline 20 µg/disc (ERV), tigecycline 15 µg/disc (TG), linezolid 10 µg/disc (LZ), nitrofurantoin 100 µg/disc (NIT), and trimethoprim 5 µg/disc (TR). The whole procedure of testing of the antibiotic susceptibility along with the interpretation of the obtained results was carried out according to European Committee on Antimicrobial Susceptibility Testing guidelines [52].
2.7. PCR Amplification of Virulence and Antibiotic Resistance Genes
PCR was carried out for the detection of eight virulence (cylB, esp, gls24, nucl, psaA, agg, gelE, and ace) and nine antibiotic resistance-related genes (erm, ermB, blaZ, vanA, aphA, mefA, gyrA, catpIP501, and aac6′-aph2″) commonly presented in clinical and environmental enterococci. PCR mixtures were prepared as described above (see Section 2.3). The reaction conditions were as follows: initial denaturation at 95 °C for 5 min, followed by 25 cycles of denaturation at 94 °C for 45 s, annealing temperature according to primer specificity (Table 1) for 45 s, extension step at 72 °C for 45 s, and a final extension step at 72 °C for 7 min. PCR products were visualized in a 1.5% agarose gel electrophoresis at 100 V for 30 min.
Table 1.
Primer pairs used for detection of virulence and antibiotic resistance genes.
2.8. Data Analysis
Welch’s t-test was used to compare the number of resistance and virulence genes, as well as the number of phenotypic antibiotic resistance profiles of isolates from different origins and within different species. Results were considered significant when p < 0.05.
3. Results
3.1. Bacterial Isolation and Identification
In total, 72 presumptive enterococcal strains were isolated from various ecological niches. Seventeen strains were isolated from the GIT of C. aspersum at the hibernation stage of the life cycle, as described previously [46]. Thirty-nine strains were isolated from different food sources (27 from Bulgarian yogurt, 2 from matured goat feta cheese, 5 from young cow feta cheese, 1 from doner kebab, and 4 from cow milk). Sixteen strains were isolated from human breast milk. The latest strains were grouped as human enterococci with non-hospital origin. All isolates appeared as pink or dark red-brownish colonies when streaked on the selective Slanetz and Bartley medium (Figure 1a). Under the microscope, they were Gram-positive cocci or coccobacilli, grouped in clusters, chains, or pairs (Figure 1b).
Figure 1.
(a) Strains YFC1 (E. faecalis) and YFC2 (E. durans) on Slanetz and Bartley medium; (b) Gram staining of strain YFC3 (E. faecalis from young feta cheese).
Three different approaches were used for species identification: PCR with genus- and species-specific primers, 16S rRNA sequencing, and MALDI-TOF mass spectrometry. The comparative analyses of the obtained sequencing results showed similarity percentage above 98–99%, which is considered a very good species identification. All obtained results for the species identification with MALDI-TOF showed score values above 2.0, which represents reliable species-level identification. Detailed information for the species identification is given in Table 2.
Table 2.
Enterococcal species identification.
Eleven species were identified: E. mundtii, E. casseliflavus, Enterococcus gilvus, Enterococcus pseudoavium, Enterococcus pallens, Enterococcus malodoratus, Enterococcus devriesei, Enterococcus gallinarum, E. durans, E. faecium, and E. faecalis. Two isolates were identified at genus level as Enterococcus spp. (BY7 and BY8, isolated from Bulgarian yoghurt). The greatest species diversity was established in the GIT of C. aspersum as eight species were identified: 29% E. mundtii, 18% E. casseliflavus, 6% E. gilvus, 12% E. pseudoavium, 6% E. pallens, 6% E. malodoratus, 12% E. devriesei, and 12% E. gallinarum (Figure 2).
Figure 2.
Species diversity in the analyzed habitats.
Two of the species (E. mundtii and E. casseliflavus), generally recognized as plant-associated enterococci [15], represent 47% of the enterococcal population of the GIT of the snail, which is a herbivore. E. faecalis and E. faecium were not detected in the GIT of C. aspersum. In contrast, these two species were predominantly identified in the food samples: 41% and 26%, respectively. The species E. durans (6%) was isolated from cow milk and young feta cheese from cow milk. All isolates from human breast milk were identified as E. faecalis.
3.2. Occurrence of cylB Gene and Production of Hemolysin
Hemolytic activity of the Enterococcus species is considered one of the basic virulence factors influencing their pathogenicity. Our results showed that there were no strains that showed phenotypic β-hemolytic activity on Columbia agar + 5% horse blood, but some strains expressed α-hemolysis (31% of all tested strains) (Figure 3a). Of the 17 strains isolated from C. aspersum GIT, 10 representatives of the species E. casseliflavus (n = 2), E. gilvus (n = 1), E. gallinarum (n = 2), E. pseudoavium (n = 1), E. pallens (n = 1), E. malodoratus (n = 1), and E. devriesei (n = 2) showed phenotypic α-hemolytic activity. The only species in this group not showing hemolytic activity was the plant-associated species E. mundtii. Of the 39 strains isolated from food samples (cow milk, Bulgarian yogurt, young feta cheese, and mature feta cheese), 11 were α-hemolytic. However, such activity was observed among E. durans (YFC2), E. casseliflavus (BY19), E. gallinarum (BY17), Enterococcus sp. (BY8), E. faecalis (n = 4), and E. faecium (n = 3). Surprisingly, only one strain isolated from human breast milk possessed α-hemolytic activity (E. faecalis BM5). Of great importance was the correlation between phenotypic hemolytic expression and the related genotypic determinants. The cylB gene is a member of the cyl operon, responsible for the synthesis of cytolysin and for β-hemolytic activity, respectively [62]. Thirteen out of all the tested strains had the cylB gene (9 from human breast milk and 4 from food samples), but none of them expressed β-hemolytic activity. Only two strains (E. faecium DK1 and E. faecalis BM5) expressed α-hemolysis and possessed the cylB gene simultaneously (Figure 3 b,c). None of the strains isolated from the GIT of the snail possessed the cylB gene.
Figure 3.
(a) Hemolysis test on Columbia agar plate supplemented with 5% horse blood; (b) α-hemolysis of E. faecalis isolated from breast milk; (c) Gel electrophoresis of PCR amplification products for the cylB gene of breast milk isolates.
3.3. Occurrence of gelE and Production of Gelatinase
The production of gelatinase and the occurrence of the related gene (gelE) were also investigated. Positive amplification for gelE was found in 35% of the tested isolates (Figure 4a). Of these, 11 had a food origin and 14 were isolated from breast milk. All of them belonged to the species E. faecalis and E. faecium. Simultaneous occurrence of phenotypic gelatinase activity and the related genotypic determinant (gelE) was observed only in three enterococcal strains (E. faecalis BM1, BM2, and BM11) isolated from human breast milk (Figure 4b). None of the snail isolates had the abovementioned gene.
Figure 4.
(a) Gel electrophoresis of PCR amplification products for the gelE gene of breast milk isolates; (b) Phenotypic gelatinase activity of breast milk isolates (BM1 and BM2) on gelatin agar.
3.4. Phenotypic Antibiotic Resistance
The obtained results from the phenotypic antibiotic resistance were interpreted according to EUCAST, 2019 [63]. All isolates were susceptible to fluoroquinolone antibiotics (ciprofloxacin, levofloxacin, and norfloxacin), teicoplanin, linezolid, nitrofurantoin, vancomycin, and imipenem. Resistance to ampicillin was observed in 21% (n = 15) of all tested strains (Table 3). Among them, 53% were E. faecalis isolated from human breast milk.
Table 3.
Distribution of phenotypic antibiotic resistance among the enterococcal isolates.
High-level gentamicin resistance (HLGR), high-level streptomycin resistance (HLSR), and quinupristin-dalfopristin resistance (RP) were established for two isolates with human origin (Figure 5a).
Figure 5.
Phenotypic antibiotic resistance test. (a) Red circles indicate HLGR and RP resistance of E. faecalis BM7 and HLSR (colonies within the zone) and RP resistance of E. faecalis BM15; statistical analyses include comparison of the number of ABR profiles (b) between the different enterococcal species and (c) between the different strain origins. Significant difference was considered p < 0.05; ns corresponds to non-significant difference.
The only strain that showed multidrug phenotypic resistance profile to three antibiotics (AMP-HLSR-RP) was E. faecalis BM15 isolated from human breast milk (1.38% from all tested strains). Phenotypic resistance to two antibiotics was observed for strains E. faecium CM1 (AMP-ERV), E. faecalis YFC1 (AMP-TG), and E. faecalis BM7 (HLGR-RP). However, the statistical analysis showed that there is no significant difference in the number of resistance profiles between E. faecalis and E. faecium (p = 0.674); E. faecalis and other Enterococcus species (p = 0.0589); and E. faecium and other Enterococcus species (p = 0.471) (Figure 5b). The human isolates (breast milk) exhibited patterns of resistance to more antibiotics compared to the other two groups (food and snail isolates). A significant difference between antibiotic resistance phenotype profiles was established between strains from food and breast milk (p = 0.017), as well as strains from snail and breast milk (p = 0.0238), but not between isolates from snail and food (p = 0.855) (Figure 5c).
3.5. Screening for Antibiotic Resistance Genes
Overall, the abundance of antibiotic resistance genes in the analyzed strains was low. Only 16 (22%) of all isolates showed the presence of one or more antibiotic resistance genes (Figure 6a).
Figure 6.
(a) Distribution of antibiotic resistance genes in enterococci from food, snail, and breast milk (labeled BM in the circus plot) (the image was generated with Circos Table Viewer v0.63-10). The outer ring of the circus plot represents the number of isolates that carry the analyzed genes. Connecting lines between the specific genes and the origin of the isolates are shown if the gene was detected in isolates from any of the three origins. Comparison of the number of antibiotic resistance genes between the different enterococcal species (b) and the different strains’ origins (c). Significant difference is considered p < 0.05.
The gene ermB, associated with macrolide resistance, was most frequently found among the analyzed Enterococcus population (15, 2%), followed by vanA (8, 3%), aphA3 (4, 2%), aac6′-aph2″ (1, 4%), and catpIP501 (1, 4%). We established that two E. faecalis strains (BM15 and BM7) had three genes encoding antibiotic resistance, which makes them unsusceptible to macrolide and aminoglycoside antibiotics. Strain BM7 showed the presence of ermB, aphA3, and aac6′-aph2″. Strain BM15 possesses the genes ermB, catpIP501, and aphA3. These data showed a correlation between genotypic and phenotypic antibiotic resistance to macrolides. However, the other gene responsible for macrolide resistance (mefA) was not detected. Unexpectedly, the gene vanA, associated with vancomycin resistance, was found in six of our strains: five E. faecalis strains from Bulgarian yogurt (BY2, BY3, BY4, BY5, BY6) and one E. faecium strain from mature feta cheese (MFC1), although no phenotypic appearance was observed.
The species comparison showed no significant differences in the number of antibiotic resistance genes (p = 0.8897 between E. faecalis and E. faecium; p = 0.0665 between E. faecalis and other Enterococcus species; and p = 0.273 between E. faecium and other Enterococcus species) (Figure 6b). On the other hand, the origin comparison showed significant differences between the snail and food distribution of antibiotic resistance genes (p = 0.0103). The above were not observed between food and breast milk isolates (p = 0.569) or between snail and breast milk isolates (p = 0.135) (Figure 6c).
Only one strain (BM7), having the HLGR gene aac6′-aph2″, showed the relevant phenotypic resistance to 30 µg/disc gentamicin. Fifteen of the isolates (20%) showed phenotypic resistance to ampicillin, but none of the strains had blaZ (codes β-lactamases) in its genome. The gene gyrA was also absent and, as expected, resistance to fluoroquinolones (ciprofloxacin, norfloxacin, and levofloxacin) was not observed.
3.6. Screening for Virulence-Associated Genes
The pathogenicity degree of the pathogenic microorganisms depends on genetically determined virulence factors. The presence of a total of eight virulence genes (cylB, esp, gls24, nucl, psaA, agg, gelE, and ace) among our enterococcal isolates was investigated (Table 4). The analyses of the distribution of the tested virulence-associated genes showed that the snail isolates did not possess any of the analyzed virulence genes. Stress protein regulator (gls24-like) was not found in the investigated enterococcal isolates. The most amplified gene among all the isolates was the gelatinase gene (gelE), followed by the Mn-transporter psaA: 31% and 28%, respectively. Both genes responsible for the synthesis of enterococcal surface protein (esp) and nuclease (nucl) were presented in 19.4% of all tested strains. Genes responsible for hemolytic activity (cylB) and collagen-binding protein (ace) were detected in 18% of the enterococcal population. Genetic determinants for aggregation substance (Agg) were found in 15.2% of the tested isolates. Four human breast milk isolates (BM5, BM6, BM9, and BM10) contain seven out of the eight screened virulence genes. The distribution of all tested virulence factors among food isolates were strain specific. The comparison of the distribution of the virulence factors in enterococcal strains isolated from the different ecological niches, showed significant differences (between snail and food isolates p = 9.6 × 10−5; food and breast milk p = 5.43 × 10−9; snail and breast milk p = 7.12 × 10−9) (Figure 7a). A similar tendency was observed between E. faecalis and E. faecium p = 1.2 × 10−5; E. faecium and other Enterococcus species p = 0.00265; E. faecalis and other Enterococcus species p = 1.52 × 10−7 (Figure 7b).
Table 4.
Distribution of genes encoding virulence factors among the tested enterococcal population.
Figure 7.
Comparison of the number of virulence genes between the different enterococcal species (a) and the different strains’ origins (b). Significant difference is considered p < 0.05.
4. Discussion
The multi-host lifestyle and unique adaptability of enterococci lead to interconnected microbiomes between mammals, invertebrates, insects, and plants which facilitate the acquisition and spread of virulence and antibiotic resistance genes (ABR) [64]. Therefore, the enterococcal populations from different biological kingdoms/origins represent reservoirs of factors causing infections in humans and plants [1,65]. In this study, we compared the pathogenic potential of enterococci isolated from diverse habitats with respect to assess their possible virulent potential for subsequent colonization of plants after potential re-return into the environment.
Our main hypothesis was that, in passing through hosts from different kingdoms, enterococci successfully adapt to the current habitat by acquiring various virulence and ABR genes, which helps them in interspecies relationships. Therefore, it is mandatory to investigate in depth the pathogenic potential of enterococci originating from various ecological niches. This accumulated knowledge could be useful in evaluating the potential risk of undesired genetic burden in the environment after the eventual re-entering of the enterococci (with acquired virulence and ABR potential) into the environment.
As a primary source of food for many organisms, plants, along with soil and water, can act as reservoirs for enterococcal species, which can subsequently join the path of pathogenicity and be transmitted through the animal chain mainly by herbivorous animals. A good example is the C. aspersum species of snail, that is in touch with all these habitats and can itself be used as a food source for other animals, including humans. By studying the microbiome of the snail, the microbial presence in its food (plants) can be deducted.
In our study, in total, 72 enterococcal strains, representatives of 11 species and isolated from seven habitats, were characterized (Table 2). In this study, we found eight enterococci species in the snail intestinal tract, with E. mundtii and E. casseliflavus being the most prevalent. E. casseliflavus was also established in Bulgarian yoghurt (fermented cow milk), derived from herbivorous warm-blooded animal (cow), but not in our isolates from raw cow milk itself. However, the persistence of E. casseliflavus in raw bovine milk has been reported [66]. Surprisingly, in the GIT of the snail, none of the isolates belonged to the E. faecium or E. faecalis species but both species dominated in all other samples. The other six species found in the GIT of C. aspersum have been generally reported to have human and animal origins [15]. It can be suggested that these species of bacteria have moved into the plants from soil and water and from there into the GIT of the snail [21]. Our results showed that the potential plant-associated isolates in the GIT and food (E. casseliflavus) did not carry genes for virulence and antibiotic resistance. Only three isolates (E. mundtii CA1, E. malodoratus CA11, and E. devriesei CA13) were phenotypically resistant to ampicillin. However, a study found that enterococci isolated from raw and processed plant-derived foods have a quite different phenotypic and molecular profile of antibiotic resistance [21]. The authors of the study found that E. faecium, E. faecalis, and E. casseliflavus strains are resistant to erythromycin, streptomycin, tigecycline, fosfomycin, and rifampicin but not to ampicillin. In that study, correlation between phenotypic high aminoglycoside resistance (HLAR) and the related genetic determinants (ant(6′)-Ia, aph(3′)-IIIa and aac(6′)-Ie-aph(2″)-la) has been reported [21]. An interesting result was that the species E. gallinarum was found in two of our samples: snail GIT and Bulgarian yoghurt. We established that no virulence or ABR was found in the snail isolates (E. gallinarum CA14 and CA15), as opposed to the Bulgarian yoghurt isolate (E. gallinarum BY17), which was found to carry the gene for ampicillin resistance. Thus, we can conclude that enterococci from snails and their food source, namely plants, did not represent any threat to human health. The acquisition of ampicillin resistance may likely happen in some of the later stages of the alimentary chain.
An important reservoir for the dissemination of enterococcal populations is the products of the lactation of mammals. For example, the most commonly isolated species from goat and sheep raw milk and their products (cheese) have been reported to be E. faecalis and E. faecium [67]. In our investigation, two similar milk products were analyzed—from cows and humans. To our knowledge, the enterococcal population in human breast milk is poorly studied. Breast milk has complex nutrient composition and contains a variety of bacterial species which influence infant health and immunity [68]. Some authors have even suggested that the enterococcal abundance corelates with the infants’ excessive weight gain [69]. The species E. faecalis, E. faecium, E. hirae, E. casseliflavus, and E. durans have been reported to be found in the milk of healthy women [69,70,71]. In our cow milk samples, we found three species—E. faecalis, E. faecium, and E. durans, which is in accordance with other authors’ findings [67]. According to some authors, of all reported plant-associated enterococcal species, only E. faecalis, E. faecium, and E. casseliflavus are dominant and best adapted to mammals [69]. It has been suggested that this selection is due to the extreme genomic plasticity of these species, allowing for facile horizontal gene transfer [45]. However, in our study, only strains of E. faecalis were identified in human breast milk. Our results showed that the distribution of the virulence and ABR genes was greatest among the enterococcal population in this ecological niche. It has been reported that E. faecalis and E. faecium have the greatest potential for causing infections as these species are the primary isolates from infected patients [65]. Some authors have suggested that the virulence and antibiotic resistance capability of some enterococci is even strain specific, considering the ecological niche they inhabit [55,72]. The statistical analyses of our results showed that the distribution of ABR genes is dependent on the ecological level but not on the species belonging. Our observations showed that the only multidrug-resistant strain was found in human breast milk. However, multidrug-resistant enterococci have also been reported in dairy products [67].
The virulence genes were much more present in the strains and a better generalization can be made. Significant differences were observed between strains from different origins as well as between different species (Figure 7). The greatest number of virulence genes was detected in E. faecalis strains from breast milk. The distribution of tested virulence-associated genes among the strains from the other samples was found to be species and even strain specific, because E. faecalis and E. faecium were not found in the snail GIT. Comparing the number of virulence genes distributed among E. faecalis and E. faecium isolates from food and human samples, we can conclude that this number drastically increased in the latter. All breast milk isolates carry genes for virulence factors, and four of them (E. faecalis BM5, BM6, BM9, and BM10) contain seven out of the eight screened virulence genes. Our results differ from those reported by Santana et al. [73], who investigated the distribution of ace, efaA, gelE, cylA, hyl, and esp virulence genes among an enterococcal population isolated from raw human breast milk. In their investigation, only two genes were detected (efaA and ace). We also noticed that two of our strains of E. durans (CM2 and CM3) isolated from cow milk did not carry any genes for virulence factors, as opposed to two strains of E. durans (YFC4 and YFC5) isolated from young feta cheese, which had the cylB gene.
Hemolytic activity is another virulence trait with great importance, as it enhances the severity of the caused infections. The production of cytolysin is associated with induced septicemia and a fivefold increased risk of acutely terminal outcome in patients [74]. In this study, none of the isolates had β-hemolytic activity, although some of the strains amplified the cylB gene. However, the ability of E. faecalis to express β-hemolysis has been reported [70]. It is known that the operon for cytolysin production is composed of five genes. The genes cylLl and cylLs encode the two structural subunits, which are then modified intracellularly by the product of the cylM gene. Then, they are transported out of the cell by a transporter encoded by the cylB gene. Once they are out of the cell, the precursor components are then activated by the cylA product. The gene cylI is responsible for the immunity of the bacteria to cytolysin. The regulation of expression is carried out by the products of two other genes—cylR1 and cylR2 [75,76,77,78]. In the present study, we established that the cylB gene did not correlate with the phenotypic hemolytic activity of the strains, which could be explained by an incomplete cyl operon. An interesting finding was that the highest percentage of α-hemolytic strains (45%) was established among species isolated from the GIT of C. aspersum (E. durans, E. casseliflavus, E. gilvus, E. pseudoavium, E. pallens, E. malodoratus, E. devriesei, and E. gallinarum). On the other hand, only one E. faecalis strain (BM4) isolated from human breast milk showed such activity. Moreover, α-hemolysis does not cause complete destruction of the red blood cells, which may limit the pathogenicity of the analyzed strains.
Gelatinase is an enzyme which is involved in the degradation of gelatin, collagen, casein, hemoglobin, etc. [79]. However, this feature of enterococcal isolates of non-hospital origin is poorly studied. For that reason, we examined the gelatinase phenotype and genotype in our collection. The expression of the gelE gene has been reported to be regulated by the products of different genes (fsrA, fsrB, and fsrC) in the fsr operon. Moreover, the expression of these genes has been described to be dependent on cell density [41]. Thus, the presence of gelE does not always produce a positive phenotype. Our results are in accordance with those reported from other authors [54,80,81]. Generally, our work demonstrates that gelE is present in 35% of our isolates, but only 4% were gelatinase producers (isolates from human breast milk). We can conclude that unexpressed gelE gene in most strains is due to one of the aforementioned reasons—lack of fsr operon or low cell density. Our observations indicate that the expression of the gelE gene and the manifestation of phenotypic gelatinase activity is a feature related to human isolates.
5. Conclusions
In this study, we tried to track the path of pathogenicity of potentially plant-associated enterococci in different levels of the alimentary chain. We established a step-by-step increase in the factors of virulence and ABR with maximal persistence in the human product—breast milk. This creates a serious problem and ambiguity—what will happen with these acquired pathogenic potential when these strains re-enter the environment and colonize the plant again? This study’s findings can be considered as a solid basis for future investigations.
Author Contributions
Conceptualization: M.P., Y.K. and P.H.; methodology: P.H.; software: M.P.; validation: P.H. and Y.K.; formal analysis: M.P.; investigation: M.P., M.T., Y.K. and P.H.; resources: T.B. and M.R.; data curation: P.H. and Y.K.; writing—original draft preparation: M.P.; writing—review and editing: Y.K. and P.H.; visualization: M.P. and Y.K.; supervision: P.H. All authors have read and agreed to the published version of the manuscript.
Funding
This research received no external funding.
Institutional Review Board Statement
Not applicable.
Informed Consent Statement
Not applicable. In Bulgaria, breast milk deposited at the Human Milk Bank, Bulgaria, is registered as food and is regulated by the Bulgarian Food Safety Authority.
Data Availability Statement
The data presented in this research are available in the manuscript.
Acknowledgments
The authors want to thank the Human Milk Bank, Bulgaria, for donating the breast milk samples.
Conflicts of Interest
The authors declare no conflicts of interest.
References
- Jha, A.K.; Bais, H.P.; Vivanco, J.M. Enterococcus faecalis mammalian virulence-related factors exhibit potent pathogenicity in the Arabidopsis thaliana plant model. Infect Immun. 2005, 73, 464–475. [Google Scholar] [CrossRef] [PubMed]
- Micallef, S.A.; Rosenberg Goldstein, R.E.; George, A.; Ewing, L.; Tall, B.D.; Boyer, M.S.; Joseph, S.W.; Sapkota, A.R. Diversity, distribution and antibiotic resistance of Enterococcus spp. recovered from tomatoes, leaves, water and soil on U.S. Mid-Atlantic farms. Food Microbiol. 2013, 36, 465–474. [Google Scholar] [CrossRef] [PubMed]
- Sadowy, E.; Luczkiewicz, A. Drug-resistant and hospital-associated Enterococcus faecium from wastewater, riverine estuary and anthropogenically impacted marine catchment basin. BMC Microbiol. 2014, 14, 66. [Google Scholar] [CrossRef] [PubMed]
- Nowakiewicz, A.; Ziółkowska, G.; Trościańczyk, A.; Zieba, P.; Gnat, S. Determination of resistance and virulence genes in Enterococcus faecalis and E. faecium strains isolated from poultry and their genotypic characterization by ADSRRS-fingerprinting. Poult. Sci. 2017, 96, 986–996. [Google Scholar] [CrossRef] [PubMed]
- Abriouel, H.; Omar, N.B.; Molinos, A.C.; López, R.L.; Grande, M.J.; Martínez-Viedma, P.; Ortega, E.; Cañamero, M.M.; Galvez, A. Comparative analysis of genetic diversity and incidence of virulence factors and antibiotic resistance among enterococcal populations from raw fruit and vegetable foods, water and soil, and clinical samples. Int. J. Food Microbiol. 2008, 123, 38–49. [Google Scholar] [CrossRef] [PubMed]
- Dubin, K.; Pamer, E.G. Enterococci and Their Interactions with the Intestinal Microbiome. Microbiol Spectr. 2014, 5, 5–6. [Google Scholar] [CrossRef]
- Franz, C.M.A.P.; Schillinger, U.; Holzapfel, W.H. Production and characterization of enterocin 900, a bacteriocin produced by Enterococcus faecium BFE 900 from black olives. Int. J. Food Microbiol. 1996, 29, 255–270. [Google Scholar] [CrossRef]
- Kizheva, Y.; Georgiev, G.; Donchev, D.; Dimitrova, M.; Pandova, M.; Rasheva, I.; Hristova, P. Cross-Over Pathogenic Bacteria Detected in Infected Tomatoes (Solanum lycopersicum L.) and Peppers (Capsicum annuum L.) in Bulgaria. Pathogens 2022, 11, 1507. [Google Scholar] [CrossRef]
- Johnston, L.M.; Jaykus, L.A. Antimicrobial resistance of Enterococcus species isolated from produce. Appl. Environ. Microbiol. 2004, 70, 3133–3137. [Google Scholar] [CrossRef]
- Mundt, J.O. Occurrence of Enterococci on Plants in aWild Environment. Appl. Microbiol. 1963, 11, 141–144. [Google Scholar] [CrossRef]
- Müller, T.; Ulrich, A.; Ott, E.M.; Müller, M. Identification of plant-associated enterococci. J. Appl. Microbiol. 2001, 91, 268–278. [Google Scholar] [CrossRef] [PubMed]
- Miller, W.R.; Murray, B.E.; Rice, L.B.; Arias, C.A. Resistance in Vancomycin-Resistant Enterococci. Infect. Dis. Clin. N. Am. 2020, 34, 751–771. [Google Scholar] [CrossRef] [PubMed]
- Godfree, A.F.; Kay, D.; Wyer, M.D. Faecal streptococci as indicators of faecal contamination in water. Soc. Appl. Bacteriol. Symp. Ser. 1997, 26, 110S–119S. [Google Scholar] [CrossRef] [PubMed]
- Ott, E.M.; Müller, T.; Müller, M.; Franz, C.M.A.P.; Ulrich, A.; Gabel, M.; Seyfarth, W. Population dynamics and antagonistic potential of enterococci colonizing the phyllosphere of grasses. J. Appl. Microbiol. 2001, 91, 54–66. [Google Scholar] [CrossRef] [PubMed]
- Byappanahalli, M.N.; Nevers, M.B.; Korajkic, A.; Staley, Z.R.; Harwood, V.J. Enterococci in the Environment. Microbiol. Mol. Biol. 2012, 76, 685. [Google Scholar] [CrossRef] [PubMed]
- Švec, P.; Vandamme, P.; Bryndová, H.; Holochová, P.; Kosina, M.; Mašlaňová, I.; Sedláček, I. Enterococcus plantarum sp. nov., isolated from plants. Int. J. Syst. Evol. Microbiol. 2012, 62 Pt 7, 1499–1505. [Google Scholar] [CrossRef] [PubMed]
- Giraffa, G. Enterococci from foods. FEMS Microbiol. Rev. 2002, 26, 163–171. [Google Scholar] [CrossRef]
- Hammerum, A.M. Enterococci of animal origin and their significance for public health. Clin. Microbiol. Infect. 2012, 18, 619–625. [Google Scholar] [CrossRef]
- Leff, J.W.; Fierer, N. Bacterial communities associated with the surfaces of fresh fruits and vegetables. PLoS ONE 2013, 8, e59310. [Google Scholar] [CrossRef]
- Mogren, L.; Windstam, S.; Boqvist, S.; Vågsholm, I.; Söderqvist, K.; Rosberg, A.K.; Lindén, J.; Mulaosmanovic, E.; Karlsson, M.; Uhlig, E.; et al. The hurdle approach-A holistic concept for controlling food safety risks associated with pathogenic bacterial contamination of leafy green vegetables. A review. Front. Microbiol. 2018, 9, 1965. [Google Scholar] [CrossRef]
- Chajęcka-Wierzchowska, W.; Zarzecka, U.; Zadernowska, A. Enterococci isolated from plant-derived food—Analysis of antibiotic resistance and the occurrence of resistance genes. Food Sci. Technol. 2021, 139, 110549. [Google Scholar] [CrossRef]
- Jahan, M.; Zhanel, G.G.; Sparling, R.; Holley, R.A. Horizontal transfer of antibiotic resistance from Enterococcus faecium of fermented meat origin to clinical isolates of E. faecium and Enterococcus faecalis. Int. J. Food Microbiol. 2015, 199, 78–85. [Google Scholar] [CrossRef] [PubMed]
- Saillant, V.; Lipuma, D.; Ostyn, E.; Joubert, L.; Boussac, A.; Guerin, H.; Brandelet, G.; Arnoux, P.; Lechardeur, D. A novel enterococcus faecalis heme transport regulator (Fhtr) senses host heme to control its intracellular homeostasis. MBio 2021, 12, e03392-e20. [Google Scholar] [CrossRef] [PubMed]
- Laissue, J.A.; Chappuis, B.B.; Müller, C.; Reubi, J.C.; Gebbers, J.O. The intestinal immune system and its relation to disease. Dig. Dis. 1993, 11, 298–312. [Google Scholar] [CrossRef] [PubMed]
- García-Díez, J.; Saraiva, C. Use of starter cultures in foods from animal origin to improve their safety. Int. J. Environ. Res. Public Health 2021, 18, 2544. [Google Scholar] [CrossRef] [PubMed]
- Gelsomino, R.; Vancanneyt, M.; Condon, S.; Swings, J.; Cogan, T.M. Enterococcal diversity in the environment of an Irish Cheddar-type cheesemaking factory. Int. J. Food Microbiol. 2001, 71, 177–188. [Google Scholar] [CrossRef] [PubMed]
- Franz, C.M.A.P.; Huch, M.; Abriouel, H.; Holzapfel, W.; Gálvez, A. Enterococci as probiotics and their implications in food safety. Int. J. Food Microbiol. 2011, 151, 125–140. [Google Scholar] [CrossRef]
- Giraffa, G. Functionality of enterococci in dairy products. Int. J. Food Microbiol. 2003, 88, 215–222. [Google Scholar] [CrossRef]
- Lengfelder, I.; Sava, I.G.; Hansen, J.J.; Kleigrewe, K.; Herzog, J.; Neuhaus, K.; Ho_man, T.; Sartor, R.B.; Haller, D. Complex bacterial consortia reprogram the colitogenic activity of Enterococcus faecalis in a gnotobiotic mouse model of chronic, immune-mediated colitis. Front. Immunol. 2019, 10, 1420. [Google Scholar] [CrossRef]
- Staley, C.; Dunny, G.M.; Sadowsky, M.J. Environmental and Animal-Associated Enterococci. Adv. Appl. Microbiol. 2014, 87, 147–186. [Google Scholar] [CrossRef]
- Shankar, P.; Chung, R.; Frank, D.A. Association of food insecurity with children’s behavioral, emotional, and academic outcomes: A systematic review. J. Dev. Pediatr. 2017, 38, 135–150. [Google Scholar] [CrossRef] [PubMed]
- Arias, C.A.; Murray, B.E. The rise of the Enterococcus: Beyond vancomycin resistance. Nat. Rev. Microbiol. 2012, 10, 266–278. [Google Scholar] [CrossRef] [PubMed]
- Klein, G.; Pack, A.; Reuter, G. Antibiotic resistance patterns of enterococci and occurrence of vancomycin-resistant enterococci in raw minced beef and pork in Germany. Appl. Environ. Microbiol. 1998, 64, 1825–1830. [Google Scholar] [CrossRef] [PubMed]
- Tendolkar, P.M.; Baghdayan, A.S.; Shankar, N. Pathogenic enterococci: New developments in the 21st century. Cell. Mol. Life Sci. 2003, 60, 2622–2636. [Google Scholar] [CrossRef] [PubMed]
- Giacobbe, D.R.; Battaglini, D.; Ball, L.; Brunetti, I.; Bruzzone, B.; Codda, G.; Crea, F.; De Maria, A.; Dentone, C.; Di Biagio, A.; et al. Bloodstream infections in critically ill patients with COVID-19. Eur. J. Clin. Investig. 2020, 50, e13319. [Google Scholar] [CrossRef] [PubMed]
- Kokkoris, S.; Papachatzakis, I.; Gavrielatou, E.; Ntaidou, T.; Ischaki, E.; Malachias, S.; Vrettou, C.; Nichlos, C.; Kanavou, A.; Zervakis, D.; et al. ICU-acquired bloodstream infections in critically ill patients with COVID-19. J. Hosp. Infect. 2021, 107, 95–97. [Google Scholar] [CrossRef] [PubMed]
- Patrier, J.; Villageois-Tran, K.; Szychowiak, P.; Ruckly, S.; Gschwind, R.; Wicky, P.H.; Gueye, S.; Armand-Lefevre, L.; Marzouk, M.; Sonneville, R.; et al. Oropharyngeal and intestinal concentrations of opportunistic pathogens are independently associated with death of SARS-CoV-2 critically ill adults. J. Crit. Care. 2022, 26, 300. [Google Scholar] [CrossRef]
- Protonotariou, E.; Mantzana, P.; Meletis, G.; Tychala, A.; Kassomenaki, A.; Vasilaki, O.; Kagkalou, G.; Gkeka, I.; Archonti, M.; Kati, S.; et al. Microbiological characteristics of bacteremias among COVID-19 hospitalized patients in a tertiary referral hospital in Northern Greece during the second epidemic wave. FEMS Microbes 2022, 2, xtab021. [Google Scholar] [CrossRef]
- Tao, S.; Chen, H.; Li, N.; Fang, Y.; Xu, Y.; Liang, W. Association of CRISPR-Cas System with the Antibiotic Resistance and Virulence Genes in Nosocomial Isolates of Enterococcus. Infect. Drug Resist. 2022, 15, 6939–6949. [Google Scholar] [CrossRef]
- Toc, D.A.; Butiuc-Keul, A.L.; Iordache, D.; Botan, A.; Mihaila, R.M.; Costache, C.A.; Colosi, I.A.; Chiorean, C.; Neagoe, D.S.; Gheorghiu, L.; et al. Descriptive Analysis of Circulating Antimicrobial Resistance Genes in Vancomycin-Resistant Enterococcus (VRE) during the COVID-19 Pandemic. Biomedicines 2022, 10, 1122. [Google Scholar] [CrossRef]
- Lopes, M.; Simões, A.; Tenreiro, R.; Joaquim, J.; Marques, F.; Crespo, M. Activity and expression of a virulence factor, gelatinase, in dairy enterococci. Int. J. Food Microbiol. 2006, 112, 208–214. [Google Scholar] [CrossRef] [PubMed]
- Leavis, H.; Top, J.; Shankar, N.; Borgen, K.; Bonten, M.; Van Embden, J.; Willems, R.J.L. A novel putative enterococcal pathogenicity island linked to the esp virulence gene of Enterococcus faecium and associated with epidemicity. J. Bacteriol. 2004, 186, 672–682. [Google Scholar] [CrossRef] [PubMed][Green Version]
- Kiruthiga, A.; Padmavathy, K.; Shabana, P.; Naveenkumar, V.; Gnanadesikan, S.; Malaiyan, J. Improved detection of esp, hyl, asa1, gelE, cylA virulence genes among clinical isolates of Enterococci. BMC Res. Notes. 2020, 13, 170. [Google Scholar] [CrossRef] [PubMed]
- Frazzon, A.P.; Gama, B.A.; Hermes, V.; Bierhals, C.G.; Pereira, R.I.; Guedes, A.G.; d’Azevedo, P.A.; Frazzon, J. Prevalence of antimicrobial resistance and molecular characterization of tetracycline resistance mediated by tet(M) and tet(L) genes in Enterococcus spp. isolated from food in Southern Brazil. World J. Microbiol. Biotechnol. 2010, 26, 365–370. [Google Scholar] [CrossRef]
- Cattoir, V. The multifaceted lifestyle of enterococci: Genetic diversity, ecology and risks for public health. Curr. Opin. Microbiol. 2022, 65, 73–80. [Google Scholar] [CrossRef] [PubMed]
- Koleva, Z.; Dedov, I.; Kizheva, J.; Lipovanska, R.; Moncheva, P.; Hristova, P. Lactic acid microflora of the gut of snail Cornu aspersum. Biotechnol. Biotechnol. Equip. 2014, 28, 627–634. [Google Scholar] [CrossRef]
- Jackson, C.R.; Fedorka-Cray, P.J.; Barrett, J.B. Use of a genus- and species-specific multiplex PCR for identification of enterococci. J. Clin. Microbiol. 2004, 42, 3558–3565. [Google Scholar] [CrossRef]
- Yoon, J.H.; Lee, S.T.; Park, Y.H. Inter- and intraspecific phylogenetic analysis of the genus Nocardioides and related taxa based on 16S rRNA gene sequences. Int. J. Syst. Bacteriol. 1998, 48, 187–194. [Google Scholar] [CrossRef]
- Carrillo, P.G.; Mardaraz, C.; Pitta-Alvarez, S.I.; Giulietti, A.M. Isolation and selection of biosurfactant-producing bacteria. World J. Microbiol. Biotechnol. 1996, 12, 82–84. [Google Scholar] [CrossRef]
- Mangia, N.P.; Saliba, L.; Deiana, P. Functional and safety characterization of autochthonous Lactobacillus paracasei FS103 isolated from sheep cheese and its survival in sheep and cow fermented milks during cold storage. Ann. Microbiol. 2019, 69, 161–170. [Google Scholar] [CrossRef]
- Bauer, A.W.; Kirby, W.M.M.; Sherris, J.C.; Turck, M. Antibiotic susceptibility testing by a standard single disk method. Am. J. Clin. Pathol. 1966, 36, 493–496. [Google Scholar] [CrossRef]
- EUCAST Version 13.1, 2023. (n.d.). Available online: http://www.eucast.org/expert_rules_and_intrinsic_resistance (accessed on 10 August 2023).
- McBride, S.M.; Fischetti, V.A.; LeBlanc, D.J.; Moellering, R.C.; Gilmore, M.S. Genetic diversity among Enterococcus faecalis. PLoS ONE 2007, 2, e582. [Google Scholar] [CrossRef] [PubMed]
- Eaton, T.J.; Gasson, M.J. Molecular Screening of Enterococcus virulence Determinants and Potential for Genetic Exchange between Food and Medical Isolates. Appl. Environ. Microbiol. 2001, 67, 1628–1635. [Google Scholar] [CrossRef] [PubMed]
- Mannu, L.; Paba, A.; Daga, E.; Comunian, R.; Zanetti, S.; Duprè, I.; Sechi, L.A. Comparison of the incidence of virulence determinants and antibiotic resistance between Enterococcus faecium strains of dairy, animal and clinical origin. Int. J. Food Microbiol. 2003, 88, 291–304. [Google Scholar] [CrossRef] [PubMed]
- van Asselt, G.J.; Vliegenthart, J.S.; Petit, P.L.C.; van de Klundert, J.A.M.; Mouton, R.P. High-level aminoglycoside resistance among enterococci and group A streptococci. J. Antimicrob. Chemother. 1992, 30, 651–659. [Google Scholar] [CrossRef]
- Garofalo, C.; Vignaroli, C.; Zandri, G.; Aquilanti, L.; Bordoni, D.; Osimani, A.; Clementi, F.; Biavasco, F. Direct detection of antibiotic resistance genes in specimens of chicken and pork meat. Int. J. Food Microbiol. 2007, 113, 75–83. [Google Scholar] [CrossRef] [PubMed]
- Aarestrup, F.M.; Agerso, Y.; Gerner–Smidt, P.; Madsen, M.; Jensen, L.B. Comparison of antimicrobial resistance phenotypes and resistance genes in Enterococcus faecalis and Enterococcus faecium from humans in the community, broilers, and pigs in Denmark. Diagn. Microbiol. Infect. Dis. 2000, 37, 127–137. [Google Scholar] [CrossRef] [PubMed]
- Jensen, L.B.; Frimodt-Møller, N.; Aarestrup, F.M. Presence of erm gene classes in gram-positive bacteria of animal and human origin in Denmark. FEMS Microbiol. Lett. 1999, 170, 151–158. [Google Scholar] [CrossRef]
- Jia, W.; Li, G.; Wang, W. Prevalence and Antimicrobial Resistance of Enterococcus Species: A Hospital-Based Study in China. Int. J. Environ. 2014, 11, 3424–3442. [Google Scholar] [CrossRef]
- Liu, C.; Zhang, Z.Y.; Dong, K.; Yuan, J.P.; Guo, X.K. Antibiotic resistance of probiotic strains of lactic acid bacteria isolated from marketed foods and drugs. Biomed. Environ. Sci. 2009, 22, 401–412. [Google Scholar] [CrossRef]
- Ferchichi, M.; Sebei, K.; Boukerb, A.M.; Karray-Bouraoui, N.; Chevalier, S.; Feuilloley, M.G.J.; Connil, N.; Zommiti, M. Enterococcus spp.: Is It a Bad Choice for a Good Use—A Conundrum to Solve? Microorganisms 2021, 9, 2222. [Google Scholar] [CrossRef] [PubMed]
- Gunnar Kahlmeter and the EUCAST Steering Committee 2019, Redefining Susceptibility Testing Categories S, I and R. Available online: https://www.eucast.org/newsiandr (accessed on 10 August 2023).
- Hiltunen, T.; Virta, M.; Laine, A.L. Antibiotic resistance in the wild: An eco-evolutionary perspective. Philos. Trans. R Soc. Lond B Biol. Sci. 2017, 372, 20160039. [Google Scholar] [CrossRef] [PubMed]
- de Kraker, M.E.; Jarlier, V.; Monen, J.C.; Heuer, O.E.; van de Sande, N.; Grundmann, H. The changing epidemiology of bacteraemias in Europe: Trends from the European Antimicrobial Resistance Surveillance System. Clin. Microbiol. Infect. 2013, 19, 860–868. [Google Scholar] [CrossRef] [PubMed]
- McAuley, C.M.; Britz, M.L.; Gobius, K.S.; Craven, H.M. Prevalence, seasonality, and growth of enterococci in raw and pasteurized milk in Victoria, Australia. J. Dairy Sci. 2015, 98, 8348–8358. [Google Scholar] [CrossRef]
- Gołaś-Prądzyńska, M.; Łuszczyńska, M.; Rola, J.G. Dairy Products: A Potential Source of Multidrug-Resistant Enterococcus faecalis and Enterococcus faecium Strains. Foods 2022, 11, 4116. [Google Scholar] [CrossRef]
- Martín, R.; Langa, S.; Reviriego, C.; Jiménez, E.; Marín, M.L.; Xaus, J.; Fernández, L.; Rodríguez, J.M. Human milk is a source of lactic acid bacteria for the infant gut. J. Pediatr. 2003, 143, 754–758. [Google Scholar] [CrossRef]
- Laursen, M.F.; Larsson, M.W.; Lind, M.V.; Larnkjær, A.; Mølgaard, C.; Michaelsen, K.F.; Bahl, M.I.; Licht, T.R. Intestinal Enterococcus abundance correlates inversely with excessive weight gain and increased plasma leptin in breastfed infants. FEMS Microbiol. Ecol. 2021, 96, fiaa066. [Google Scholar] [CrossRef]
- Wajda, Ł.; Ostrowski, A.; Błasiak, E.; Godowska, P. Enterococcus faecium Isolates Present in Human Breast Milk Might Be Carriers of Multi-Antibiotic Resistance Genes. Bacteria 2022, 1, 66–87. [Google Scholar] [CrossRef]
- Huang, M.S.; Cheng, C.C.; Tseng, S.Y.; Lin, Y.L.; Lo, H.M.; Chen, P.W. Most commensally bacterial strains in human milk of healthy mothers display multiple antibiotic resistance. MicrobiologyOpen 2019, 8, e00618. [Google Scholar] [CrossRef]
- Franz, C.M.; Muscholl-Silberhorn, A.B.; Yousif, N.M.; Vancanneyt, M.; Swings, J.; Holzapfel, W.H. Incidence of virulence factors and antibiotic resistance among Enterococci isolated from food. Appl. Environ. Microbiol. 2001, 67, 4385–4389. [Google Scholar] [CrossRef]
- Santana, L.A.M.; Andrade, N.N.N.; da Silva, L.S.C.; Oliveira, C.N.T.; de Brito, B.B.; de Melo, F.F.; Souza, C.L.; Marques, L.M.; Oliveira, M.V. Identification and characterization of resistance and pathogenicity of Enterococcus spp. in samples of donor breast milk. World J. Clin. Pediatr. 2020, 9, 53–62. [Google Scholar] [CrossRef] [PubMed]
- Huycke, M.M.; Spiegel, C.A.; Gilmore, M.S. Bacteremia caused by hemolytic, high-level gentamicin-resistant Enterococcus faecalis. Antimicrob. Agents Chemother. 1991, 35, 1626–1634. [Google Scholar] [CrossRef] [PubMed]
- Gilmore, M.S.; Segarra, R.A.; Booth, M.C.; Bogie, C.P.; Hall, L.R.; Clewell, D.B. Genetic structure of the Enterococcus faecalis plasmid pAD1-encoded cytolytic toxin system and its relationship to lantibiotic determinants. J. Bacteriol. 1994, 176, 7335–7344. [Google Scholar] [CrossRef] [PubMed]
- Haas, W.; Shepard, B.D.; Gilmore, M.S. Two-component regulator of Enterococcus faecalis cytolysin responds to quorum-sensing autoinduction. Nature 2002, 415, 84–87. [Google Scholar] [CrossRef] [PubMed]
- Haas, W.; Gilmore, M.S. Molecular nature of a novel bacterial toxin: The cytolysin of Enterococcus faecalis. Med. Microbiol. Immunol. 1999, 187, 183–190. [Google Scholar] [CrossRef]
- Ike, Y.; Clewell, D.B.; Segarra, R.A.; Gilmore, M.S. Genetic analysis of the pAD1 hemolysin/bacteriocin determinant in Enterococcus faecalis: Tn917 insertional mutagenesis and cloning. J. Bacteriol. 1990, 172, 155–163. [Google Scholar] [CrossRef]
- Vergis, E.N.; Shankar, N.; Chow, J.W.; Hayden, M.K.; Snydman, D.R.; Zervos, M.J.; Linden, P.K.; Wagener, M.M.; Muder, R.R. Association between the presence of enterococcal virulence factors gelatinase, hemolysin, and enterococcal surface protein and mortality among patients with bacteremia due to Enterococcus faecalis. Clin. Infect. Dis. 2002, 35, 570–575. [Google Scholar] [CrossRef]
- Semedo, T.; Santos, M.A.; Lopes, M.F.; Figueiredo Marques, J.J.; Barreto Crespo, M.T.; Tenreiro, R. Virulence factors in food, clinical and reference Enterococci: A common trait in the genus? Syst. Appl. Microbiol. 2003, 26, 13–22. [Google Scholar] [CrossRef]
- Creti, R.; Imperi, M.; Bertuccini, L.; Fabretti, F.; Orefici, G.; Di Rosa, R.; Baldassarri, L. Survey for virulence determinants among Enterococcus faecalis isolated from different sources. J. Med. Microbiol. 2004, 53 Pt 1, 13–20. [Google Scholar] [CrossRef]
Disclaimer/Publisher’s Note: The statements, opinions and data contained in all publications are solely those of the individual author(s) and contributor(s) and not of MDPI and/or the editor(s). MDPI and/or the editor(s) disclaim responsibility for any injury to people or property resulting from any ideas, methods, instructions or products referred to in the content. |
© 2023 by the authors. Licensee MDPI, Basel, Switzerland. This article is an open access article distributed under the terms and conditions of the Creative Commons Attribution (CC BY) license (https://creativecommons.org/licenses/by/4.0/).